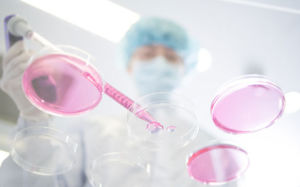

삼성, 전세계 스마트폰 1위 수성…"애플 몸값 낮출 때 AI로 차별화"
1분기 이어 2분기에도 스마트폰 출하량 1위…점유율 18.9% 차지
中서 판매 가격 낮춘 애플, 15.8%로 2위…샤오미 14.8%로 맹추격
![[서울=뉴시스] 김혜진 기자 = 삼성전자가 자사 첫 AI(인공지능) 스마트폰 '갤럭시 S24' 시리즈를 전세계 주요 국가에서 공식 출시한 31일 서울 마포구 삼성스토어 홍대를 찾은 시민이 갤럭시 S24 시리즈 제품을 살펴보고 있다. 갤럭시 S24 시리즈는 한국, 미국, 영국, 프랑스, 독일, 인도, 싱가포르 등을 시작으로 전세계 120여개국에 순차 출시된다. 2024.01.31. jini@newsis.com](https://img1.newsis.com/2024/01/31/NISI20240131_0020215732_web.jpg?rnd=20240131155656)
[서울=뉴시스] 김혜진 기자 = 삼성전자가 자사 첫 AI(인공지능) 스마트폰 '갤럭시 S24' 시리즈를 전세계 주요 국가에서 공식 출시한 31일 서울 마포구 삼성스토어 홍대를 찾은 시민이 갤럭시 S24 시리즈 제품을 살펴보고 있다. 갤럭시 S24 시리즈는 한국, 미국, 영국, 프랑스, 독일, 인도, 싱가포르 등을 시작으로 전세계 120여개국에 순차 출시된다. 2024.01.31. [email protected]
[서울=뉴시스]심지혜 기자 = 삼성전자가 2개 분기 연속 전세계 스마트폰 출하량 1위를 차지했다. 생성형 인공지능(AI) 기능을 탑재한 갤럭시S24가 글로벌 흥행에 성공하면서 선두 자리를 지킨 것으로 풀이된다.
15일 글로벌 시장조사업체 IDC에 따르면 2분기 전세계 스마트폰 출하량은 전년 동기 대비 6.5%증가한 2억8540만대로 집계됐다.
IDC는 스마트폰 수요가 아직 완전히 회복된 것은 아니지만 4개 분기 연속 출하량이 늘어난 것에 의미가 있다고 평가했다.
브랜드별로 살펴보면 삼성전자의 출하량은 5390만대로 18.9%의 점유율을 차지, 1위 자리를 수성했다. 애플은 4520만대를 출하, 점유율 15.8%로 뒤를 이었다.
삼성전자는 지난해 4분기 애플에 1위 자리를 내줬으나 1분기 만에 다시 탈환했다. IDC는 삼성전자가 주력 제품에 대한 전략을 집중하는 동시에 선제적으로 AI 기능을 탑재하면서 1위를 차지할 수 있었다고 분석했다.
애플에 대해서는 중국 등의 지역에서 성과가 개선되면서 2위 자리를 지킬 수 있었다고 진단했다. 애플은 중국에서 일부 모델에 대해 최대 20%까지 할인된 가격에 판매했는데, 이를 통해 점유율을 방어할 수 있었던 것으로 풀이된다.
![[서울=뉴시스] 글로벌 시장조사업체 IDC에 따르면 2분기 전세계 스마트폰 출하량은 전년 동기 대비 6.5%증가한 2억8540만대로 집계됐다. (사진=IDC 홈페이지) *재판매 및 DB 금지](https://img1.newsis.com/2024/07/15/NISI20240715_0001602266_web.jpg?rnd=20240715150238)
[서울=뉴시스] 글로벌 시장조사업체 IDC에 따르면 2분기 전세계 스마트폰 출하량은 전년 동기 대비 6.5%증가한 2억8540만대로 집계됐다. (사진=IDC 홈페이지) *재판매 및 DB 금지
3위는 4230만대 출하량을 기록한 중국 샤오미가 차지했다. 점유율은 14.8%로 애플과의 점유율 격차를 1%p 수준으로 좁혔다.
1분기만 해도 애플과 샤오미가 각각 17.3%, 14.1%로 3.2%p 차이가 났는데 줄어든 것이다.
다음으로는 출하량 2590만대를 기록한 비보(9.1%)와 2580만대를 출하한 오포(9%)가 뒤를 이었다.
IDC는 샤오미와 비보가 중국과 신흥 시장에서 판매량 성과를 거두면서 두 자릿수 성장을 나타냈다고 분석했다. 샤오미는 전년 동기 대비 27.4% 늘었고, 비보는 21.9% 증가했다.
오포의 경우 중국 외의 지역에서 영향력을 지속 확장한 결과라고 봤다.
IDC는 앞으로 스마트폰 시장이 고가 모델과 생성형 AI 탑재 스마트폰에 집중될 것으로 내다봤다. 특히 생성형 AI 스마트폰 시장 성장이 빠르게 이뤄질 것으로 예상했다.
IDC는 “올해 생성형 AI 스마트폰 출하량은 2억34000만대로 전체 스마트폰 시장의 19%를 차지할 것”이라고 전망했다.
◎공감언론 뉴시스 [email protected]
Copyright © NEWSIS.COM, 무단 전재 및 재배포 금지